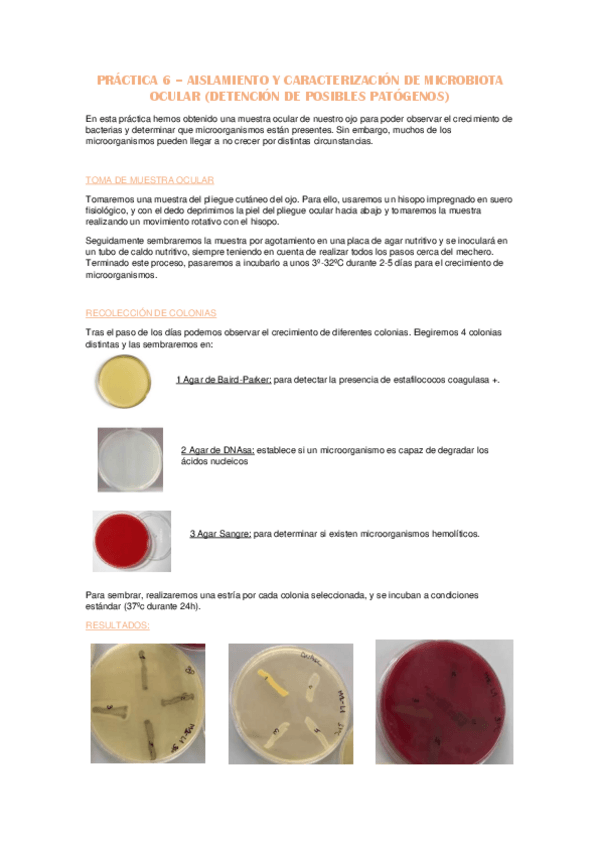

Biología
apuntes
-
APUNTES BIOLOGÍA 1°
He publicado nuevos apuntes de 1º Biología: APUNTES BIOLOGÍA 1°
apuntes
-
Todos los temas
He publicado nuevos apuntes de 1º Biología: Todos los temas
apuntes
-
RESÚMENES BIOLOGÍA
He publicado nuevos apuntes de 1º Biología: RESÚMENES BIOLOGÍA
apuntes
-
Apuntes temas
He publicado nuevos apuntes de 1º Biología: Apuntes temas
He publicado nuevos apuntes de 1º Biología: Tema-7-Agentes-responsables-de-infecciones-oculares.pdf
He publicado nuevos apuntes de 1º Biología: Tema-6-Division-celular-cultivo-y-crecimiento-microbiano.pdf
He publicado nuevos apuntes de 1º Biología: Tema-5-Estructura-composicion-y-funcion-de-la-celula-procariota.pdf
He publicado nuevos apuntes de 1º Biología: Tema-4-Microorganismos-eucariotas.pdf
He publicado nuevos apuntes de 1º Biología: Tema-1-Pertinencia-de-la-biologia-en-optica.pdf
He publicado nuevos apuntes de 1º Biología: Tema-2-Introduccion-a-la-microbiologia.pdf
He publicado nuevos practicas de 1º Biología: Practica-11-El-globo-ocular.pdf
He publicado nuevos practicas de 1º Biología: Practica-3-Observacion-de-celulas-eucariotas-y-procariotas.pdf
He publicado nuevos practicas de 1º Biología: Practica-2-La-tectina-histologica.pdf
He publicado nuevos practicas de 1º Biología: Practica-1-Manejo-y-uso-del-microscopio-optico-compuesto.pdf
He publicado nuevos apuntes de 1º Biología: Biologia-recuperacion.pdf
He publicado nuevos practicas de 1º Biología: Practica-n1-biologia.pdf
He publicado nuevos practicas de 1º Biología: Practica-10-biologia.pdf
He publicado nuevos practicas de 1º Biología: Practica-9-biologia.pdf
He publicado nuevos practicas de 1º Biología: practica-8-biologia.pdf
He publicado nuevos practicas de 1º Biología: practica-3-biologia.pdf
He publicado nuevos practicas de 1º Biología: Practica-2-Biologia.pdf
practicas
-
Informes prácticas
He publicado nuevos practicas de 1º Biología: Informes prácticas
practicas
-
Prácticas
He publicado nuevos practicas de 1º Biología: Prácticas
He publicado nuevos apuntes de 1º Biología: TEORIA-PRACTICAS-BIOLOGIA.pdf
apuntes
-
Temas
He publicado nuevos apuntes de 1º Biología: Temas
practicas
-
Practicas
He publicado nuevos practicas de 1º Biología: Practicas
practicas
-
PRACTICAS BIOLOGIA
de nada chicos
He publicado nuevos apuntes de 1º Biología: TEMA-7.-MICROBIOLOGIA.pdf
He publicado nuevos apuntes de 1º Biología: TEMA-6.-MICROBIOLOGIA.pdf
He publicado nuevos apuntes de 1º Biología: TEMA-5.-MICROBIOLOGIA.pdf
He publicado nuevos apuntes de 1º Biología: TEMA-4.-MICROBIOLOGIA.pdf
He publicado nuevos apuntes de 1º Biología: TEMA-3.-MICROBIOLOGIA.pdf
He publicado nuevos apuntes de 1º Biología: TEMA-2.-MICROBIOLOGIA.pdf
apuntes
-
prácticas biología
He publicado nuevos apuntes de 1º Biología: prácticas biología
He publicado nuevos apuntes de 1º Biología: Practica-10--Genetica-Mendeliana.pdf
He publicado nuevos apuntes de 1º Biología: Practica-9.-TejidosII.pdf
He publicado nuevos apuntes de 1º Biología: Practica-no6.-Aislamiento-y-caracterizacion-de-la-microbiota-ocular-deteccion-de-posibles-patogenos.pdf
He publicado nuevos apuntes de 1º Biología: Practica-no5.-Factores-que-influyen-en-el-crecimiento-microbiano-aislamiento-siembra-e-incubacion-Antibiogramas..pdf
He publicado nuevos apuntes de 1º Biología: Practica-2-biologia.-TECNICA-HISTOLOGICA.pdf
He publicado nuevos apuntes de 1º Biología: PRACTICA-1-Manejo-y-uso-del-microscopio-optico-compuesto..pdf